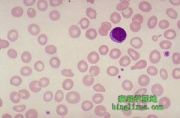

由Admin上传
来自医学百科
本特殊页面展示所有上传的文件。
| 日期 | 名称 | 缩略图 | 尺寸 | 说明 | 版本 |
|---|---|---|---|---|---|
| 2014年1月18日 (六) 19:27 | Bkb4p.jpg (文件) |  |
45 KB | 1 | |
| 2014年1月18日 (六) 19:27 | Bk8up.jpg (文件) |  |
35 KB | 1 | |
| 2014年1月18日 (六) 19:27 | Bkdcl.jpg (文件) |  |
41 KB | 1 | |
| 2014年1月18日 (六) 19:26 | Bk97o.jpg (文件) | |
10 KB | 1 | |
| 2014年1月18日 (六) 19:26 | Bk0xm.jpg (文件) |  |
63 KB | 1 | |
| 2014年1月18日 (六) 19:26 | Glysor98.jpg (文件) |  |
35 KB | 1 | |
| 2014年1月18日 (六) 19:26 | Bkk61.jpg (文件) |  |
3 KB | 1 | |
| 2014年1月18日 (六) 19:26 | Bk0o2.jpg (文件) |  |
184 KB | 1 | |
| 2014年1月18日 (六) 19:26 | Bk3r5.jpg (文件) |  |
54 KB | 1 | |
| 2014年1月18日 (六) 19:26 | Gv6d0mgs.jpg (文件) |  |
7 KB | 1 | |
| 2014年1月18日 (六) 19:26 | Glytsob1.jpg (文件) |  |
26 KB | 1 | |
| 2014年1月18日 (六) 19:26 | Bk1ih.jpg (文件) |  |
3 KB | 1 | |
| 2014年1月18日 (六) 19:26 | Bkpb0.jpg (文件) |  |
60 KB | 1 | |
| 2014年1月18日 (六) 19:26 | Gunutm33.jpg (文件) |  |
35 KB | 1 | |
| 2014年1月18日 (六) 19:26 | Bkgsc.jpg (文件) |  |
79 KB | 1 | |
| 2014年1月18日 (六) 19:26 | Gq0ll72l.jpg (文件) |  |
15 KB | 1 | |
| 2014年1月18日 (六) 19:26 | Bkp5y.jpg (文件) |  |
94 KB | 1 | |
| 2014年1月18日 (六) 19:25 | Bkohq.jpg (文件) |  |
48 KB | 1 | |
| 2014年1月18日 (六) 19:25 | Bkan5.jpg (文件) |  |
47 KB | 1 | |
| 2014年1月18日 (六) 19:25 | Gm8ta23s.gif (文件) |  |
6 KB | 1 | |
| 2014年1月18日 (六) 19:25 | Bk8vu.jpg (文件) |  |
15 KB | 1 | |
| 2014年1月18日 (六) 19:25 | Bk0a9.jpg (文件) |  |
76 KB | 1 | |
| 2014年1月18日 (六) 19:25 | Bkpg1.jpg (文件) |  |
113 KB | 1 | |
| 2014年1月18日 (六) 19:25 | Guz1brtl.jpg (文件) |  |
17 KB | 1 | |
| 2014年1月18日 (六) 19:25 | Bk4fi.jpg (文件) |  |
133 KB | 1 | |
| 2014年1月18日 (六) 19:25 | Bkd6l.jpg (文件) |  |
7 KB | 1 | |
| 2014年1月18日 (六) 19:25 | Gj6wi5n0.jpg (文件) |  |
17 KB | 1 | |
| 2014年1月18日 (六) 19:25 | Bkkjb.jpg (文件) |  |
18 KB | 1 | |
| 2014年1月18日 (六) 19:25 | Glytcaxv.jpg (文件) |  |
34 KB | 1 | |
| 2014年1月18日 (六) 19:25 | Bkdvw.jpg (文件) |  |
48 KB | 1 | |
| 2014年1月18日 (六) 19:24 | Guwhiald.jpg (文件) |  |
3 KB | 1 | |
| 2014年1月18日 (六) 19:24 | Bkdv3.jpg (文件) |  |
208 KB | 1 | |
| 2014年1月18日 (六) 19:24 | Bk9ag.jpg (文件) |  |
4 KB | 1 | |
| 2014年1月18日 (六) 19:24 | Bke5c.jpg (文件) |  |
151 KB | 1 | |
| 2014年1月18日 (六) 19:24 | Gj6xogb3.jpg (文件) |  |
13 KB | 1 | |
| 2014年1月18日 (六) 19:24 | Gmomehzh.jpg (文件) | 7 KB | 1 | ||
| 2014年1月18日 (六) 19:24 | Bk60y.jpg (文件) |  |
10 KB | 1 | |
| 2014年1月18日 (六) 19:24 | Bk7rh.jpg (文件) |  |
9 KB | 1 | |
| 2014年1月18日 (六) 19:24 | Bkgfk.jpg (文件) |  |
122 KB | 1 | |
| 2014年1月18日 (六) 19:24 | Bk9hs.jpg (文件) |  |
32 KB | 1 | |
| 2014年1月18日 (六) 19:24 | Bk7z3.jpg (文件) |  |
32 KB | 1 | |
| 2014年1月18日 (六) 19:24 | Bkjd9.jpg (文件) |  |
23 KB | 1 | |
| 2014年1月18日 (六) 19:24 | Gmoppmp2.jpg (文件) |  |
2 KB | 1 | |
| 2014年1月18日 (六) 19:23 | Gq0oqkl0.jpg (文件) |  |
13 KB | 1 | |
| 2014年1月18日 (六) 19:23 | Bknst.jpg (文件) |  |
7 KB | 1 | |
| 2014年1月18日 (六) 19:23 | Bkf4r.jpg (文件) |  |
5 KB | 1 | |
| 2014年1月18日 (六) 19:23 | Goqr3nsy.jpg (文件) |  |
7 KB | 1 | |
| 2014年1月18日 (六) 19:23 | Bkhi0.jpg (文件) |  |
28 KB | 1 | |
| 2014年1月18日 (六) 19:23 | Bkgeb.jpg (文件) |  |
13 KB | 1 | |
| 2014年1月18日 (六) 19:23 | Bk9fx.jpg (文件) |  |
21 KB | 1 |